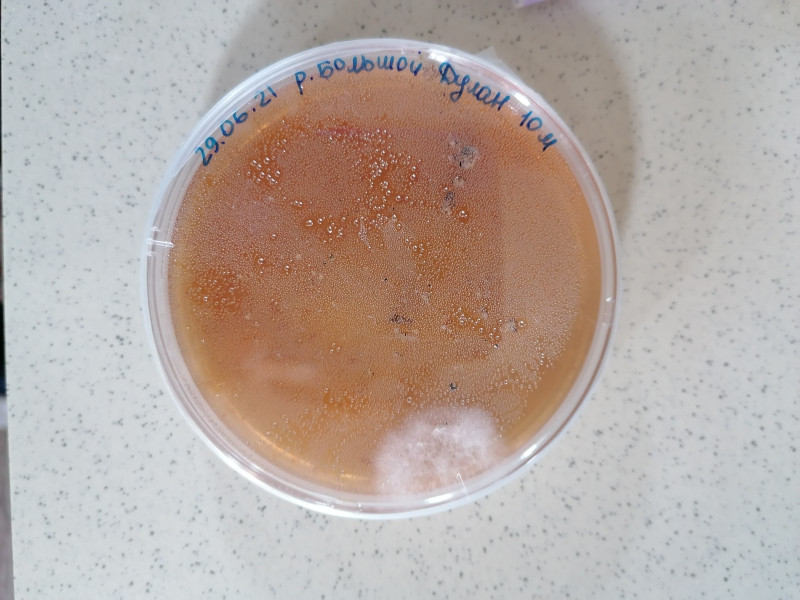
Fig_6

Экспедиция на НИС «Папанин» с 28 июня по 05 июля 2021 года
С 28 июня по 05 июля 2021 года на НИС «Папанин» проведены экспедиционные работы по всему Байкалу в рамках выполнения темы государственного задания № 0279-2021-0010 «Генетика сообществ байкальских организмов: структура генофонда, стратегии консервации» (рук. д.б.н. Д.Ю. Щербаков).
Цель экспедиции – отбор проб байкальских гидробионтов (амфиподы, моллюски, многоклеточные зеленые водоросли) для последующих морфометрических, генетических и физиологических исследований. В экспедиционных условиях были выполнены посевы грунта на селективные среды для дальнейшего изучения видового разнообразия грибов и их биохимических свойств.
Сбор материала проводился с помощью скребков и сачков на урезе воды, гидробиологической драгой и дночерпателем Петерсена (S=0.025 м2) с глубин от 10 до 300 метров. Всего было отобрано 18 прибрежных проб зоо- и фитобентоса, 18 проб грунта для изучения микобиоты.